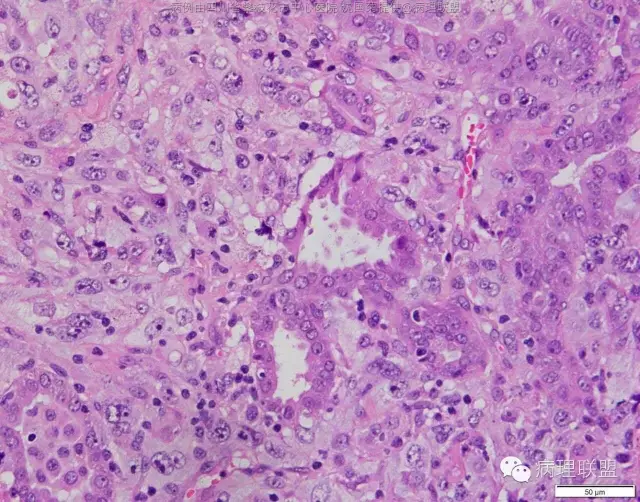
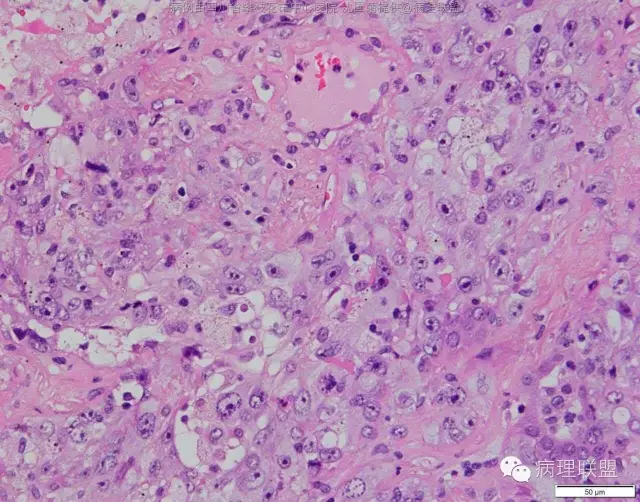
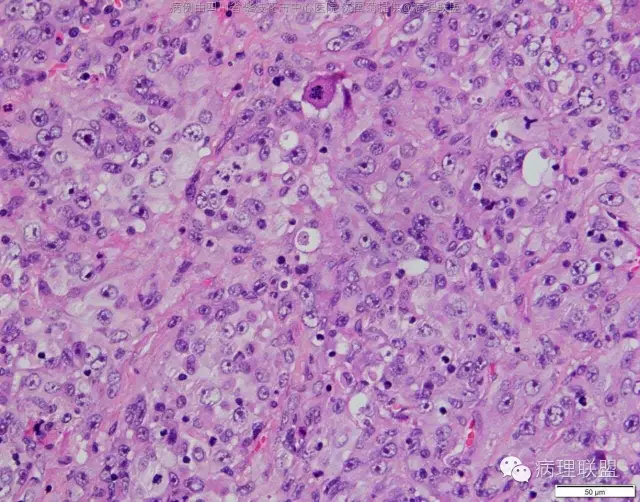
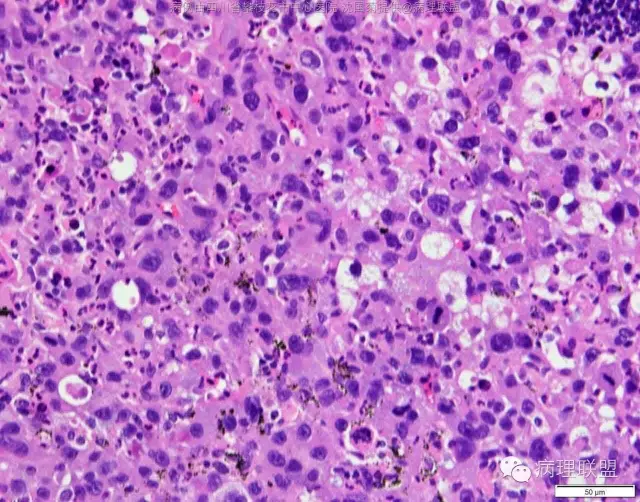

亚专科 ▪ 微信汇
M/47 肺部占位( 肺大细胞癌?)
作者:管理员
时间:
M/47 肺部占位,大小2*1*0.6cm(病例由四川攀枝花市中心医院 沈国菊提供,致谢!)
@沈国菊 考虑腺癌可能 有结果吗?
@张丽 免疫组化腺癌,鳞癌,神经内分泌,恶黑标记均为阴性,只有广谱CK跟Vimentin阳性,准备发大细胞癌
@沈国菊 肺大细胞癌的签发有时是个排他性诊断,我的体会:大细胞的标准:按淋巴细胞直径3倍来算,需要大于这个值,不能等于(从图给出,符合)。神经内分泌的标记(CD56 SYN CgA)完全阴性的可能性不是没有,建议重做试试;细胞的异型性大(符合);Ki67的指数高,应该非常高(您这里没有给出)。这仅仅是我个人体会,我说的不一定正确。
感谢您的精彩病例,采图非常漂亮,并且有标尺(特别赞)。魏老师,Ki-67阳性大于90%,送检7组淋巴结6/7见肿瘤转移。
符合的
上一篇:
M/53 右食指包块(内生性软骨瘤)
下一篇:
F/20 枕部包块20年-皮肤脑膜瘤